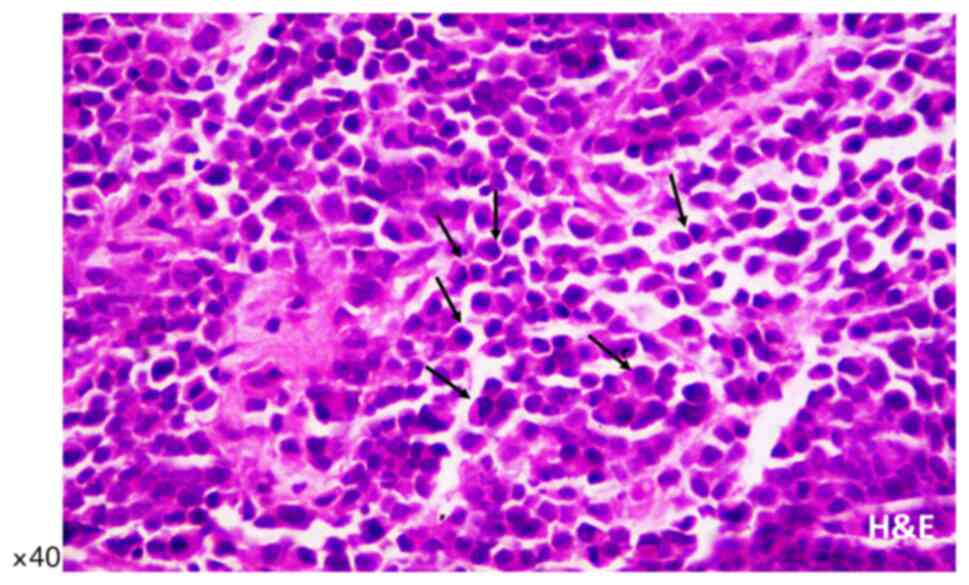

Introduction
According to Global Cancer Statistics (GLOBOCAN)
2020, prostate cancer is the third most commonly diagnosed
malignancy (7.3%), preceded only by lung (11.4%) and colorectal
cancer (10.0%) (1). Prostate
cancer is the most commonly diagnosed cancer in men in over 50% of
countries in the world. Prostate cancer incidence varies
substantially between countries with a high Human Development Index
(HDI), such as Europe and North America, and those with a low HDI,
such as Asia (37.5 vs. 11.3 per 100,000 people, respectively).
However, cases are increasing in Asian countries such as Japan and
Singapore where, historically, this cancer had a low incidence rate
and prostate-specific antigen (PSA) testing was minimal (2). The introduction of PSA testing
worldwide allowed the detection of preclinical prostate cancers,
decreasing the mortality rates for prostate cancer in most
high-income countries. The etiology of prostate cancer is not clear
yet, and except the advanced age, family history of this
malignancy, and genetic predisposition (e.g., BRAC1 and
BRAC2, Lynch syndrome), other factors including smoking,
excess body weight, and nutritional factors may increase the risk
of prostate cancer. In addition, although the Gleason score is
currently the best prognostic indicator for this cancer, grading of
prostate cancer based on its molecular profile is considered an
independent factor to predict poor outcomes in patients with low
Gleason scores (3). The above
makes clear the need for a better understanding of the
pathophysiology of prostate cancer and whether variable histologic
features present different molecular phenotypes.
The vast majority of prostatic cancers are acinar
adenocarcinomas, including eight histological variants, according
to 2016 the World Health Organization (WHO) classification. The
atrophic, pseudo-hyperplastic, microcystic, and foamy variants have
a false benign appearance and can be misdiagnosed. The signet
ring-like cell, pleomorphic giant cell, and sarcomatoid variants
harbor prognostic significance, with a worse prognosis compared to
the usual acinar adenocarcinoma (3-5).
Plasmacytoid is a rare variant of acinar prostatic adenocarcinoma
and has been reported little. Plasmacytoid carcinoma appeared with
a single ring-like cell pattern and has been characterized by the
presence of discohesive cells with eccentrically placed nuclei and
abundant eosinophilic cytoplasm (5-7).
In the literature, there are two previous descriptions of prostate
carcinoma with plasmacytoid features (8,9). In
these cases, the patients had lymphovascular invasion and
advanced-stage disease (Gleason score >8). In the first case,
Al-Hussain et al (8) used
histological and immunohistochemical analyses and identified a
plasmacytoid variant of prostatic adenocarcinoma with signet
ring-like cell appearance, undermining benign urothelium. This
tumor was initially considered histologically as a plasmacytoid
variant of urothelial carcinoma, given the lack of a morphological
counterpart in the prostate and the distinct features of a loss of
E-cadherin. However, PSA and NKX3 immunoreactivity confirmed a
prostatic adenocarcinoma with plasmacytoid features. Subsequently,
Nguyen et al (9) reviewed a
series of radical prostatectomies with high-grade prostatic
adenocarcinoma and found a tumor with a component of single-cell
infiltration, and significant morphological overlap with the
plasmacytoid variant of urothelial carcinoma, diffuse-type gastric
adenocarcinoma, and lobular breast carcinoma. Immunohistochemical
analysis for NKX3.1 and PSA confirmed a prostatic adenocarcinoma
with plasmacytoid features.
Plasmacytoid carcinomas have been described in the
urothelium (5-7,10-14),
the ureter (15), and the renal
pelvis (16), while plasmacytoid
morphology is not limited to urothelial carcinoma and plasmacytoid
prostate carcinoma, which presents PSA and NKX 3.1
immunoreactivity, must be distinguished from other plasmacytoid
neoplasms. However, the plasmacytoid variant of both urothelial and
prostate carcinomas shares some common molecular features. In
particular, the distinctive feature of E-Cadherin loss suggests
that it may play a role in the development of the plasmacytoid
pattern of both bladder and prostate carcinoma (17-19)
while it may be accompanied by aberrant expression of p120 catenin
(20). The loss of E-cadherin and
the abnormal protein expression of p120 catenin, found by
immunohistochemical analysis, strongly suggest changes in
CDH1 encoding E-Cadherin. However, studies have shown that
other molecular pathways may also play a role in this
histopathological phenotype (8,21).
Specifically, Al-Hussain et al (8) identified several putative driver
alterations in FANCA, MET, SMARCA4, in addition to
frameshift deletions in BRAF and KDR, and loss of
copy number at the RB1 locus. However, they found no genomic
alterations in the CDH1 gene.
Plasmacytoid carcinomas of the genitourinary tract
are associated with locally advanced disease and a tendency for
lymph node involvement at onset (5,9,10,12,13).
Plasmacytoid prostate tumors can be locally invasive and
misdiagnosed as urothelial carcinomas. This may emphasize the
importance of identifying and reporting more cases and better
understanding their pathophysiological features. Here we report a
case of a plasmacytoid variant of acinar adenocarcinoma of the
prostate with an irregular immunohistochemical phenotype on biopsy
and summarize the known literature on plasmacytoid feature in the
genitourinary system. We also discuss the importance of
distinguishing this variant, which is characterized by a unique
histological feature and molecular phenotype, from other prostate
carcinomas and neoplasms of the urinary tract that may be mandatory
due to the clinical and prognostic implications of this
diagnosis.
Case report
A 62-year-old male proceeded to the outpatient
urology department with urinary retention, hematuria, weakness, and
weight loss. The digital rectal examination was deemed malignant
enlargement. Laboratory findings showed elevated levels of prostate
specific antigen (PSA: 43.6 ng/ml). Ultrasound showed invasion of
the right seminal vesicle. The patient underwent transrectal
ultrasound to guide prostate biopsy. Prostate biopsy cores were
sent to the Department of Pathology (University of Thessaly,
Greece) for diagnosis.
Samples were fixed in 10% neutral buffered formalin
(pH 7.4) for 24 h, at room temperature, dehydrated in a graded
series of ethanol and xylene, and embedded into paraffin wax. Three
µm sections were used for histological staining (hematoxylin and
eosin, H&E; hematoxylin incubation for 3 min at room
temperature; eosin incubation for 5 min at room temperature).
Serial 4 µm sections were used for immunohistochemical (IHC)
chromogenic staining. We used antibodies against Cytokeratin
cocktail (clone AE1/AE3, 1:200, 313M-16, Cell Marque Corp.), high
molecular weight Cytokeratin, (clone 34BE12, 1:100, Z2019ML, Zeta
Corp.), PSA (clone ER-PR8, 1:50, M0750, Dako; Agilent Technologies,
Inc.), p63 (clone 4A4, 1:100, M7317, Dako; Agilent Technologies,
Inc.), GATA-3 (clone L50-823, 1:100, Z2227ML, Zeta Corp.),
synaptophysin (clone 27G12, 1:100, SYNAP-299-L-CE, Leica
Biosystems, Newcastle Ltd.) and Ε-cadherin (clone NCH-38, 1:100,
M3612, Dako; Agilent Technologies, Inc.). All primary antibodies
were incubated at room temperature, for 30 min. Prior to the
antibody incubation, 3% hydrogen peroxide was used for blocking
endogenous peroxidase (15 min at room temperature). Positive
staining was visualized with Bright Vision Ultimate plus kit
[two-component detection system Goat Anti-Mouse/Rabbit IgG HRP
(horseradish peroxidase), ready to use, 30 min incubation at room
temperature; Immunologic, Holland], using DAB as chromogen.
Microscopic examination and image analysis after histological and
IHC staining was performed using laboratory rectifier microscope
Nikon 50i (Nikon Solutions Co. Ltd.), with trioptic head and
digital camera Basler (Basler AG), and mvSlide software
(Microvisioneer).
Microscopic examination of biopsy sections was
performed after histological staining (hematoxylin and eosin,
H&E) and revealed diffuse, neoplastic infiltration of prostate
biopsy cores. The malignant single-cell pattern was presented with
a plasmacytoid appearance with abundant cytoplasm and eccentrically
placed hyperchromatic nuclei with small occasional nucleoli and
variable intracytoplasmic features (Fig. 1), as previously described by
Al-Hussain et al (8) and
Nguyen et al (9), while
there were a few mitotic figures. Immunohistochemical staining
revealed abundant positivity for cytokeratins CKAE1/AE3 (Fig. 2A) and PSA (Fig. 2B), while tumor cells were negative
for p63, cytokeratin 34BE12, GATA3, synaptophysin, and E-Cadherin
(Fig. 2C). Specifically, compared
to the normal prostatic acini that showed positive membranous
immunoreactivity (Fig. 2C-a), the
tumor cells were found to be negative for E-cadherin (Fig. 2C-b). Genomic analysis for
CDH1 alterations was not performed for the present case
(Table I). The diagnosis was
high-grade prostatic adenocarcinoma Gleason score of 5+5 (total
score 10) with plasmacytoid features. Computed tomography (CT) scan
did not reveal any metastases at the time of diagnosis. Our
histological and laboratory findings, including clinical stage
T3bNxM0, Gleason score 10 (5+5) and PSA (before treatment) 43.6
ng/ml, supported a high-risk prostate carcinoma, according to
National Comprehensive Cancer Network (NCCN) guidelines, which
defined the baseline of localized high-risk prostate cancer as PSA
>20 ng/ml, clinical stage ≥T3a and Gleason score ≥8(22) (Table
II). This case was diagnosed by biopsy. However, no tissue
specimens or patient's follow-up were provided after radical
prostatectomy to our hospital. The patient is now alive, six months
after diagnosis.
 | Table ICases of prostatic adenocarcinoma
with plasmacytoid features and the immunohistochemical and
molecular phenotypes. |
Table I
Cases of prostatic adenocarcinoma
with plasmacytoid features and the immunohistochemical and
molecular phenotypes.
| A, Previous
cases |
|---|
| | Immunohistochemical
staining | |
|---|
| First author,
year | Number of
cases | Positive | Negative | Molecular
findings | (Refs.) |
|---|
| Al-Hussain et
al, 2019 | 1 | NKX3.1, PSA, CK8/18
and PSAP | 34BE12, CK20, p63,
Desmin, CD38, κ and λ light chains, chromogranin, synaptophysin,
GATA3, E-cadherin and CD45 | Next generation
Sequencing (HiSeq 2500 platform; Illumina, Inc.) Missense mutations
in FANCA (p. L1339F), MET (p. R547G) and
SMARCA4 (p.Y820N) Frameshift deletions in BRAF and
KDR Large copy number loss of RB1 locus No genomic
alterations in CDH1 | (8) |
| Nguyen et
al, 2020 | 9 | NKX3.1, PSA, p120
and catenin | E-cadherin | Somatic alterations
in CDH1 | (9) |
| B, Current
study |
| | Immunohistochemical
staining | |
| First author,
year | Number of
cases | Positive | Negative | Molecular
findings | (Refs.) |
| N/A | 1 | CKAE1/AE3 and
PSA | 34BE12, p63,
synaptophysin, GATA3 and E-cadherin | N/A | N/A |
 | Table IICases of prostatic adenocarcinoma
with plasmacytoid features and the histological and laboratory
findings. |
Table II
Cases of prostatic adenocarcinoma
with plasmacytoid features and the histological and laboratory
findings.
| A, Previous
cases |
|---|
| | Tumor
characteristics | PSA | |
|---|
| First author,
year | Survived/total
casesa | TNM staging | Gleason score | Before
treatment | After
treatment | (Refs.) |
|---|
| Al-Hussain et
al, 2019 | 0/1 | T4N1M1b | 10 (5+5) | 50.7 ng/ml | 11.2 ng/ml | (8) |
| Nguyen et
al, 2020 | 4/9 |
T2N0M0-T3bN1M1b | 8 (3+5) to 9
(5+4) | N/A | Undetectable | (9) |
| B, Current
case |
| | Tumor
characteristics | PSA | |
| First author,
year | Survived/total
casesa | TNM staging | Gleason score | Before
treatment | After
treatment | (Refs.) |
| N/A | 1/1 | T3bNXM0 | 10 (5+5) | 43.6 ng/ml | N/A | N/A |
Discussion
Prostatic acinar adenocarcinoma represents a
clinically and histologically heterogeneous disease. Several
variants of prostatic adenocarcinoma have been recognized. The
pathologist should recognize these variants because some of them
present diagnostic challenges while others have prognostic
implications. Variants of prostatic carcinomas, such as atrophic,
pseudo-hyperplastic, microcystic, and foamy gland, can mimic benign
conditions and therefore pose diagnostic challenges (23-28),
while pleomorphic giant cell adenocarcinoma and sarcomatoid
carcinoma are aggressive variants of prostate cancer (29-31).
Pleomorphic giant cell adenocarcinoma is an extremely aggressive
variant with extensive metastases, with death reported soon after
diagnosis (29,30). Also, Hansel and Epstein (31) reported 42 cases of sarcomatoid
carcinoma of the prostate, in which half of the patients developed
metastasis, while one-year mortality was found in 20% of the
patients. Because of the diverse morphological patterns of prostate
cancer, grading systems based on architectural methods, such as the
Gleason score, are used to determine prostate cancer aggression
(32-35).
Two grades are assigned for each patient and typical total Gleason
scores range from 6-10. A total Gleason score of 8 or higher
describes high-grade prostate cancers that are likely to spread
rapidly. Signet ring-like cell variant of prostate cancer is
usually an aggressive tumor with an architectural model that most
of the tumor is grade 4 and the next largest section of the tumor
is grade 5 (Gleason score 4+5=9), while rarely we can see signet
ring-like cell vacuoles in well-formed glands of the pattern 3. The
histologic pattern, which defines a high Gleason score, is
characterized by single infiltrating cells (34), and has significant morphological
overlap with other carcinoma variants developing into a diffuse,
discohesive pattern with minimal stromal reaction, such as the
plasmacytoid variant of urothelial carcinoma (36), diffuse-type gastric cancer
(37,38), and lobular breast cancer (39), and is highly associated with
CDH1 alterations. This histological pattern is a rare
variant of prostatic adenocarcinoma that has been classified as
plasmacytoid carcinoma.
The first reported case of plasmacytoid carcinoma
was described in the urothelium by Sahin et al (40). This tumor was characterized by
lytic tumors involving the ribs and skull, which is confused as
multiple myeloma. Plasmacytoid pathology was initially thought to
be diagnostic of B-cell lymphoma and plasmacytoma, which is why
many misdiagnoses have been made. However, plasmacytoid appearance
can also is found in cells of non-B cell hematopoietic neoplasm and
various non-hematopoietic derivatives. In 2006, two non-invasive
bladder tumors, resembling plasmacytoma, were reported by Coyne and
Sim (41). Subsequently, several
other plasmacytoid urothelial carcinomas were described (5-7,10-13,42,43),
as well as cases of the ureter and renal pelvis (15,16).
Here, we describe a new case of plasmacytoid adenocarcinoma of the
prostate, diagnosed on tumor core biopsy, presenting histological
and molecular characteristics consistent with those recently
described by Al- Hussain et al (8) and Nguyen et al (9), as shown Table I. We also emphasize the importance
of obtaining immunohistochemical data as we explore the
differential diagnosis of prostate cancer and distinguish it from
other carcinomas with plasmacytoid features such as those of the
genitourinary system.
In our presenting case, we analyzed several core
biopsies of a prostate tumor and identified high-grade cancer with
a Gleason score of 5+5 (total score 10), in which tumor cells
showed a plasmacytoid appearance, specifically, abundant cytoplasm
and eccentrically placed hyperchromatic nuclei (Fig. 1). Our immunohistochemical data,
which document tumor cells with strong immunoreactivity for
cytokeratins AE1/AE3 and PSA, but negative for urothelial markers,
such as p63, cytokeratin 34BE12, and GATA3, synaptophysin which is
a neuroendocrine marker, and cell-cell adhesion molecule E-cadherin
(Fig. 2C), which is particularly
indicative of CDH1 alterations, are consistent with data
from two previous reports of prostate plasmacytoid tumors (8,9).
Specifically, Al-Hussain et al (8) showed prostate tumor cells with a
plasmacytoid appearance that were positive for cytokeratin 8/18,
but negative for E-cadherin (Table
I). Nguyen et al (9)
also described a single-cell, high-grade adenocarcinoma of the
prostate with a distinct subtype of plasmacytoid features with loss
of E-cadherin and positive expression of cytoplasmic p120 catenin.
It is worth mentioning that these previously described plasmacytoid
features were analyzed from radical prostatectomy or local
metastases, while here we present for the first time a case of
plasmacytoid carcinoma described by prostate biopsy cores. This
observation may emphasize the importance of differential diagnosis
in prostate biopsy.
E-cadherin is one of the key molecules which form
adhesive intercellular connections between epithelial cells
(44,45) and may play a key role in metastasis
of prostate cancer. Loss of E-cadherin expression is a hallmark of
the epithelial-to-mesenchymal transition (EMT) process, while
epithelial cells that lose their ability to adhere to adjacent
cells and extracellular matrix proteins acquire a mesenchymal
phenotype (46). It is considered
that a decrease in E-cadherin expression may occur during the
development of prostate carcinoma, leading to migration, invasion,
and eventual metastasis (47).
However, the results of the studies are controversial, and the loss
or aberrant expression of E-cadherin has been associated with a
poor prognosis of prostate carcinoma through different mechanisms
(47). In particular, the loss of
E-cadherin and the abnormal expression of p120 catenin protein,
through immunohistochemical analysis, strongly suggest changes in
CDH1. Plasmacytoid urothelial carcinoma, lobular breast
carcinoma, and diffuse gastric carcinoma have previously been shown
to cause CDH1 alterations leading to loss of function, along
with loss of expression of E-cadherin, which is in the cell
membrane (36). However, it has
been previously suggested that other molecular pathways may also
play a role in the prostate plasmacytoid variant, including
alterations in FANCA, MET, SMARCA4, in addition to
frameshift deletions in BRAF and KDR, and a large
loss of copy number at the RB1 locus (8). Nevertheless, all these tumors
typically present morphological characteristics of tumor cells that
develop into a discohesive single-cell pattern due to the loss of
cell-cell adhesions. In particular, the single-cell pattern of
tumor infiltration in prostatic adenocarcinoma is clinically
important as it meets the definition of the highest grade of
Gleason-based architecture (48).
Our data showed E-cadherin deficiency, using immunohistochemical
analysis (8), in plasmacytoid
adenocarcinoma of the prostate with a Gleason score of 5+5 (total
score 10), which supports a high-grade tumor with a single-cell
pattern.
Taking all the above, the morphology of plasmacytoid
tumors in the genitourinary system is not exclusive to urothelial
carcinoma. Therefore, a differential diagnosis between high-grade
adenocarcinoma of the prostate compared to high-grade urothelial
carcinoma is needed to access the prognosis and provide the right
treatment. As in our case, this can be aided by using a targeted
panel of antibodies in immunohistochemistry, such as PSA (Fig. 2B), prostatic acid phosphatase
(PAP), and NKX3.1 or protein antibodies to prostatic
adenocarcinoma, as well as GATA3, p63, and 34BE12 antibodies to
urothelial carcinoma (49).
Specifically, PSA and GATA3 are recommended as first-line markers
(49). In addition, high-grade
prostatic adenocarcinoma can be distinguished from urinary bladder
adenocarcinoma using the prostatic markers PSA, PAP, and prostein
(49). Immunohistochemical
analysis for villin, thrombomodulin, CDX2, and carcinoembryonic
antigen (CEA) can be also used to indicate urinary bladder
adenocarcinoma (49). In the case
presented here, we obtained immunohistochemical data that confirmed
the diagnosis of prostate carcinoma, distinguishing it from other
carcinomas of the genitourinary system.
Overall, clinical features, immunohistochemical data
including E-cadherin immunoreactivity, and the molecular profile in
the prognosis of therapy selection of prostate tumors still need
further validation (50).
Al-Hussein et al (8) showed
a case of plasmacytoid prostate metastatic tumor negative for
E-Cadherin, but without CDH1 genomic alterations (Table I). This tumor initially responded
to antiandrogen therapy, which is considered the first-line
treatment for prostate cancer with clinically detected metastases
(51). However, the patient of
that case died 6 months after diagnosis (Table II). In contrast, in our case, a
plasmacytoid prostate tumor that was not metastatic at the time of
diagnosis was negative for E-Cadherin, although it was not analyzed
for CDH1 mutations (Table
I). This tumor was treated by radical prostatectomy, which is
considered a treatment option for men with a localized prostate
tumor. In addition, the patient is now alive, six months after
diagnosis (Table II). Based on
the above, assessing the association between E-cadherin loss along
with CDH1 or other genomic alterations in plasmacytoid
prostate tumor development and/or disease prognosis after
treatment, like hormonal therapy, may be worth further
investigation through preclinical models and therapy treatment
studies.
In conclusion, the recognition of the newly
described plasmacytoid variant of prostatic adenocarcinoma can be
made in tissue biopsies. Identification of the irregular
immunophenotype of this tumor may support the role of somatic
changes in CDH1 in the development of the plasmacytoid
pattern with loss of E-cadherin. Although some limitations may be
mentioned, such as the evaluation of a non-extensive panel of
immunohistochemical or molecular markers, including the lack of
CDH1 genomic analysis, due to small biopsy material, and
access to clinical information, we believe that the presentation of
a new rare prostatic carcinoma variant may contribute to better
understanding this uncommon histological pattern that may be
mandatory due to the clinical and prognostic implications of this
diagnosis.
Acknowledgements
Not applicable.
Funding
Funding: No funding was received.
Availability of data and materials
The datasets used and/or analyzed during the current
study are available from the corresponding author on reasonable
request.
Authors' contributions
KZ, DPV, GKK and MI were involved in conceiving and
designing the study. KZ, GKK and MI contributed to patient data
collection. MI, KZ and DPV confirm the authenticity of all the raw
data. KZ, DPV, GKK and MI contributed to the interpretation of
data. KZ, DV and MI were involved in the preparation of the
original draft. DPV, MI, GKK and KZ critically revised the
manuscript. All authors have read and approved the final
manuscript.
Ethics approval and consent to
participate
The patient was admitted to the General University
Hospital of Larissa (Larissa Thessaly, Greece), which is a teaching
hospital, and the patient signed a written consent for
participation and publication of their associated data.
Patient consent for publication
Not applicable.
Competing interests
The authors declare that they have no competing
interests.
References
|
1
|
Sung H, Ferlay J, Siegel RL, Laversanne M,
Soerjomataram I, Jemal A and Bray F: Global cancer statistics 2020:
GLOBOCAN estimates of incidence and mortality worldwide for 36
cancers in 185 countries. CA Cancer J Clin. 71:209–249.
2021.PubMed/NCBI View Article : Google Scholar
|
|
2
|
Baade PD, Youlden DR and Krnjacki LJ:
International epidemiology of prostate cancer: Geographical
distribution and secular trends. Mol Nutr Food Res. 53:171–184.
2009.PubMed/NCBI View Article : Google Scholar
|
|
3
|
Humphrey PA: Histopathology of prostate
cancer. Cold Spring Harb Perspect Med. 7(a030411)2017.PubMed/NCBI View Article : Google Scholar
|
|
4
|
Kweldam CF, van Leenders GJ and van der
Kwast T: Grading of prostate cancer: A work in progress.
Histopathology. 74:146–160. 2019.PubMed/NCBI View Article : Google Scholar
|
|
5
|
Lopez-Beltran A, Requena MJ, Montironi R,
Blanca A and Cheng L: Plasmacytoid urothelial carcinoma of the
bladder. Hum Pathol. 40:1023–1028. 2009.PubMed/NCBI View Article : Google Scholar
|
|
6
|
Fox MD, Xiao L, Zhang M, Kamat AM,
Siefker-Radtke A, Zhang L, Dinney CP, Czerniak B and Guo CC:
Plasmacytoid urothelial carcinoma of the urinary bladder: A
clinicopathologic and immunohistochemical analysis of 49 cases. Am
J Clin Pathol. 147:500–506. 2017.PubMed/NCBI View Article : Google Scholar
|
|
7
|
Cockerill PA, Cheville JC, Boorjian SA,
Blackburne A, Thapa P, Tarrell RF and Frank I: Outcomes following
radical cystectomy for plasmacytoid urothelial carcinoma: Defining
the need for improved local cancer control. Urology. 102:143–147.
2017.PubMed/NCBI View Article : Google Scholar
|
|
8
|
Al-Hussain T, Haffner MC, Altaweel WM and
Epstein JI: Plasmacytoid acinar adenocarcinoma of the prostate: A
newly described variant of prostate cancer. Hum Pathol. 94:86–91.
2019.PubMed/NCBI View Article : Google Scholar
|
|
9
|
Nguyen JK, Chen YY, Magi-Galluzzi C and
McKenney JK: Clinicopathological study of Gleason pattern 5
prostatic adenocarcinoma with ‘single-cell’ growth reveal 2
distinct types, one with ‘plasmacytoid ‘features. Am J Pathol.
44:1635–1642. 2020.PubMed/NCBI View Article : Google Scholar
|
|
10
|
Li Q, Assel M, Benfante NE, Pietzak EJ,
Herr HW, Donat M, Cha EK, Donahue TF, Bochner BH and Dalbagni G:
The impact of plasmacytoid variant histology on the survival of
patients with urothelial carcinoma of bladder after radical
cystectomy. Eur Urol Focus. 5:104–108. 2019.PubMed/NCBI View Article : Google Scholar
|
|
11
|
Dayyani F, Czerniak BA, Sircar K, Munsell
MF, Millikan RE, Dinney CP and Siefker-Radtke AO: Plasmacytoid
urothelial carcinoma, a chemosensitive cancer with poor prognosis,
and peritoneal carcinomatosis. J Urol. 189:1656–1661.
2013.PubMed/NCBI View Article : Google Scholar
|
|
12
|
Ericson KJ, Thomas L and Lee BH:
Plasmacytoid variant urothelial carcinoma: Clinicopathologic
outcomes and experience with neoadjuvant chemotherapy. J Clin
Oncol. 37(483)2019.
|
|
13
|
Diamantopoulos LN, Khaki AR, Vakar-Lopez
F, Tretiakova MS, Gore JL, Schade GR, Psutka SP, Hsieh AC, Lee JK,
Hsieh AC, et al: Patient (pt) characteristics, treatment patterns,
outcomes and prognostic factors in plasmacytoid urothelial
carcinoma (PUC). J Clin Oncol. 37 (Suppl 15):e16007. 2019.
|
|
14
|
Straccia P, Martini M, Sacco E, Bassi PF
and Pierconti F: Cytological features of micropapillary and
plasmacytoid variants of urothelial carcinoma. Diagn Cytopathol.
48:111–117. 2020.PubMed/NCBI View
Article : Google Scholar
|
|
15
|
Jibril A and Steven AC: Plasmacytoid
urothelial carcinoma of ureter with retroperitoneal metastasis: A
case report. Am J Case Rep. 19:158–162. 2018.PubMed/NCBI View Article : Google Scholar
|
|
16
|
Takada-Owada A, Nozawa Y, Onozaki M, Noda
S, Jamiyan T, Tokura Y, Nakazato Y, Kamai T and Ishida K:
Plasmacytoid urothelial carcinoma of renal pelvis with positive
zinc finger E-box-binding homeobox 1: A case report. Diagn Pathol.
15(124)2020.PubMed/NCBI View Article : Google Scholar
|
|
17
|
Keck B, Wach S, Kunath F, Bertz S, Taubert
H, Lehmann J, Stöckle M, Wullich B and Hartmann A: Nuclear
E-cadherin expression is associated with the loss of membranous
E-cadherin, plasmacytoid differentiation and reduced overall
survival in urothelial carcinoma of the bladder. Ann Surg Oncol.
20:2440–2445. 2013.PubMed/NCBI View Article : Google Scholar
|
|
18
|
Lim MG, Adsay NV, Grignon DJ and Osunkoya
AO: E-cadherin expression in plasmacytoid, signet ring cell and
micropapillary variants of urothelial carcinoma: Comparison with
usual-type high-grade urothelial carcinoma. Mod Pathol. 24:241–247.
2011.PubMed/NCBI View Article : Google Scholar
|
|
19
|
Ma B, Khazali A, Shao H, Jiang Y and Wells
A: Expression of E-cadherin and specific CXCR3 isoforms impact each
other in prostate cancer. Cell Commun Signal.
17(164)2019.PubMed/NCBI View Article : Google Scholar
|
|
20
|
Sangoi AR, Chan E, Stohr BA and Kunju LP:
Invasive plasmacytoid urothelial carcinoma: A comparative study of
E-cadherin and P120 catenin. Hum Pathol. 102:54–59. 2020.PubMed/NCBI View Article : Google Scholar
|
|
21
|
Palsgrove DN, Taheri D, Springer SU, Cowan
M, Guner G, Rodriguez MA, Pena MDC, Wang Y, Kinde I, Ricardo BFP,
et al: Targeted sequencing of plasmacytoid urothelial carcinoma
reveals frequent TERT promoter mutations. Hum Pathol. 85:1–9.
2019.PubMed/NCBI View Article : Google Scholar
|
|
22
|
Mohler JL, Antonarakis ES, Armstrong AJ,
D'Amico AV, Davis BJ, Dorff T, Eastham JA, Enke CA, Farrington TA,
Higano CS, et al: Prostate cancer version 2.2019, NCCN clinical
practise guidelines in oncology. J Natl Compr Canc Netw.
17:479–505. 2019.PubMed/NCBI View Article : Google Scholar
|
|
23
|
Nelson RS and Epstein JI: 1996. Prostatic
carcinoma with abundant xanthomatous cytoplasm. Foamy gland
carcinoma. Am J Surg Pathol. 20:419–426. 1996.PubMed/NCBI View Article : Google Scholar
|
|
24
|
Cina SJ and Epstein JI: Adenocarcinoma of
the prostate with atrophic feature. Am J Surg Pathol. 21:289–295.
1997.PubMed/NCBI View Article : Google Scholar
|
|
25
|
Humphrey PA, Kaleem Z, Swanson PE and
Vollmer RT: Pseudohyperplastic prostatic adenocarcinoma. Am J Surg
Pathol. 22:1239–1246. 1998.PubMed/NCBI View Article : Google Scholar
|
|
26
|
Wolf AN and Epstein JI: Pseudohyperplastic
prostatic adenocarcinoma in needle biopsy and simple prostatectomy.
Am J Surg Pathol. 24:1039–1046. 2000.PubMed/NCBI View Article : Google Scholar
|
|
27
|
Yaskiv O, Cao D and Humphrey PA:
Microcystic adenocarcinoma of the prostate: A variant of
pseudohyperplastic and atrophic patterns. Am J Surg Pathol.
34:556–561. 2010.PubMed/NCBI View Article : Google Scholar
|
|
28
|
Levi AW and Epstein JI: Pseudohyperplastic
prostatic adenocarcinoma in needle biopsy and simple prostatectomy.
Am J Surg Pathol. 24:1039–1046. 2000.PubMed/NCBI View Article : Google Scholar
|
|
29
|
Lopez-Beltran A, Eble JN and Bostwick DG:
Pleomorphic giant cell carcinoma of the prostate. Arch Pathol Lab
Med. 129:683–685. 2005.PubMed/NCBI View Article : Google Scholar
|
|
30
|
Parwani AV, Herawi M and Epstein JI:
Pleomorphic giant cell adenocarcinoma of the prostate: Report of 6
cases. Am J Surg Pathol. 30:1254–1259. 2006.PubMed/NCBI View Article : Google Scholar
|
|
31
|
Hansel DE and Epstein JI: Sarcomatoid
carcinoma of the prostate: A study of 42 cases. Am J Surg Pathol.
30:1316–1321. 2006.PubMed/NCBI View Article : Google Scholar
|
|
32
|
Epstein JI, Amin MB, Reuter VE and
Humphrey PA: Contemporary gleason grading of prostatic carcinoma:
An update with discussion of practical issues to implement the 2014
international society of urological pathology (ISUP) consensus
conference on gleason grading of prostatic carcinoma. Am J Surg
Pathol. 41:e1–e7. 2017.PubMed/NCBI View Article : Google Scholar
|
|
33
|
Humphrey PA: Variants of acinar
adenocarcinoma of the prostate mimicking benign conditions. Mod
Pathol. 31 (S1):S64–S70. 2018.PubMed/NCBI View Article : Google Scholar
|
|
34
|
Gottipati S, Warncke J, Vollmer R and
Humphrey PA: Usual and unusual histologic patterns of high Gleason
score 8 to 10 adenocarcinoma of the prostate in needle biopsy
tissue. Am J Surg Pathol. 36:900–907. 2012.PubMed/NCBI View Article : Google Scholar
|
|
35
|
Epstein JI, Egevad L, Amin MB, Delahunt B,
Srigley JR and Humphrey PA: Grading Committee. The 2014
international society of urological pathology (ISUP) consensus
conference on gleason grading of prostatic carcinoma: Definition of
grading patterns and proposal for a new grading system. Am J Surg
Pathol. 40:244–252. 2016.PubMed/NCBI View Article : Google Scholar
|
|
36
|
Al-Ahmadie HA, Iyer G, Lee BH, Scott SN,
Mehra R, Bagrodia A, Jordan EJ, Gao SP, Ramirez R, Cha EK, et al:
Frequent somatic CDH1 loss-of-function mutations in plasmacytoid
variant bladder cancer. Nat Genet. 48:356–358. 2016.PubMed/NCBI View
Article : Google Scholar
|
|
37
|
Schrader KA, Masciari S, Boyd N, Wiyrick
S, Kaurah P, Senz J, Burke W, Lynch HT, Garber JE and Huntsman DG:
Hereditary diffuse gastric cancer: Association with lobular breast
cancer. Fam Cancer. 7:73–82. 2008.PubMed/NCBI View Article : Google Scholar
|
|
38
|
Oliveira C, Senz J, Kaurah P, Pinheiro H,
Sanges R, Haegert A, Corso G, Schouten J, Fitzgerald R, Vogelsang
H, et al: Germline CDH1 deletions in hereditary diffuse gastric
cancer families. Hum Mol Genet. 18:1545–1555. 2009.PubMed/NCBI View Article : Google Scholar
|
|
39
|
Keller G, Vogelsang H, Becker I, Hutter J,
Ott K, Candidus S, Grundei T, Becker KF, Mueller J, Siewert JR and
Höfler H: Diffuse type gastric and lobular breast carcinoma in a
familial gastric cancer patient with an E-cadherin germline
mutation. Am J Pathol. 155:337–342. 1999.PubMed/NCBI View Article : Google Scholar
|
|
40
|
Sahin AA, Myhre M, Ro JY, Sneige N,
Dekmezian RH and Ayala AG: Plasmacytoid transitional cell
carcinoma. Report of a case with initial presentation mimicking
multiple myeloma. Acta Cytol. 35:277–280. 1991.PubMed/NCBI
|
|
41
|
Coyne JD and Sim E: Urothelial neoplasia
with plasmacytoid morphology. Histopathology. 48:200–201.
2006.PubMed/NCBI View Article : Google Scholar
|
|
42
|
Wang YG, Perera M and Gleeson J:
Plasmacytoid urothelial carcinoma of the bladder with extensive
scrotal wall invasion. Urol Ann. 8:381–383. 2016.PubMed/NCBI View Article : Google Scholar
|
|
43
|
Fritsche HM, Burger M, Denzinger S, Legal
W, Goebell PJ and Hartmann A: Plasmacytoid urothelial carcinoma of
the bladder: Histological and clinical features of 5 cases. J Urol.
180:1923–1927. 2008.PubMed/NCBI View Article : Google Scholar
|
|
44
|
Bougen NM, Amiry N, Yuan Y, Kong XJ,
Pandey V, Vidal LJ, Perry JK, Zhu T and Lobie PE: Trefoil factor 1
suppression of E-CADHERIN enhances prostate carcinoma cell
invasiveness and metastasis. Cancer Lett. 332:19–29.
2013.PubMed/NCBI View Article : Google Scholar
|
|
45
|
Nauseef JT and Henry MD:
Epithelial-to-mesenchymal transition in prostate cancer: Paradigm
or puzzle? Nat Rev Urol. 8:428–439. 2011.PubMed/NCBI View Article : Google Scholar
|
|
46
|
Lee HM, Hwang KA and Choi KC: Diverse
pathways of epithelial mesenchymal transition related with cancer
progression and metastasis and potential effects of endocrine
disrupting chemicals on epithelial mesenchymal transition process.
Mol Cell Endocrinol. 457:103–113. 2017.PubMed/NCBI View Article : Google Scholar
|
|
47
|
Chunthapong J, Seftor EA, Khalkhali-Ellis
Z, Seftor RE, Amir S, Lubaroff DM, Heidger PM Jr and Hendrix MJ:
Dual roles of E-cadherin in prostate cancer invasion. J Cell
Biochem. 91:649–661. 2004.PubMed/NCBI View Article : Google Scholar
|
|
48
|
Epstein JI: Prostate cancer grading: A
contemporary photomontage. Am J Surg Pathol. 40(137)2016.PubMed/NCBI View Article : Google Scholar
|
|
49
|
Epstein JI, Egevad L, Humphrey PA and
Montironi R: Members of the ISUP Immunohistochemistry In Diagnostic
Urologic Pathology Group. Best practices recommendations in the
application of immunohistochemistry in the prostate: Report from
the international society of urologic pathology consensus
conference. Am J Surg Pathol. 38:e6–e19. 2014.PubMed/NCBI View Article : Google Scholar
|
|
50
|
Dehm SM and Tindall DJ: Molecular
regulation of androgen action in prostate cancer. J Cell Biochem.
99:333–344. 2006.PubMed/NCBI View Article : Google Scholar
|
|
51
|
Zhang X, Zhang Z, Chen S, Jiang J, Qi R,
Mi X, Zhang X, Xi Y, Zheng H and Hua B: Prognostic significance of
E-cadherin expression in prostatic carcinoma: A protocol for
systematic review and meta-analysis. Medicine (Baltimore).
99(e19707)2020.PubMed/NCBI View Article : Google Scholar
|